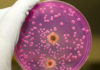
Jednostavni napitak protiv nabujale kandide

Nemojte kod prvih simptoma bolesti odmah krenuti u ljekarnu, već spremite ovu korisnu i ljekovitu smjesu! Možete je također koristiti u kompleksnom liječenju respiratornih oboljenja. Možete je dodavati u mlijeko ili čaj.
Mnogi od vas su već imali neko iskustvo sa kurkumom (turmerikom). Netko ju je koristi kao začin, mnogi su pripremali napitak Zlatno mlijeko, a netko je samo vidio kesice ovog žutog praha i pitao se čemu služi, piše uspesnazena.com.
Kurkuma i med
Ali, malo tko zna da je kurkuma, u kombinaciji s medom neprocjenjiv prirodni lijek.
On posjeduje vrlo jako protuupalno djelovanje, koje ne samo da uništava bakterije koje izazivaju bolesti, već i promiče prirodnu obranu.
Za razliku od sintetičkih antibiotika, kojima su prepunjene ljekarne, takav lijek nema negativan učinak na crijevnu mikrofloru.
Kurkuma sadrži kurkumin, polifenolni identificiran kao osnovni aktivni sastojak, koji postiže više od 150 potencijalno terapijskih djelatnosti, a uključuje antioksidativna, protuupalna i antikancerogena svojstva.
Konzumiranjem kurkume i meda značajno se poboljšava probava i povećava se aktivnost korisne flore u crijevima.
O tome svjedoče potvrde znanstvene literature.
U Ayurvedi je ovo tradicionalni lijek protiv prehlade.
Zato nemojte kod prvih simptoma bolesti odmah krenuti u ljekarnu, već spremite korisnu i ljekovitu smjesu – “Zlatni med”, miješanjem kurkume u prahu i meda.
Zlatni med – najjači prirodni antibiotik – recept
Kod prvih simptoma prehlade pripremite smjesu koju ćete koristiti 3 dana.
Sastojci:
100 gr meda
1 žlica kurkume
Postupak:
U 100 gr meda dodajte 1 punu jušnu žlicu kurkume.
Dobro promiješajte i stavite u staklenku.
Konzumiranje:
Uzimati kod prvih simptoma prehlade:
1. dan – na svakih sat vremena po pola čajne žlice, tijekom cijelog dana
2. dan – svakih dva sata po pola čajne žlice
3. dan – tri puta dnevno po pola čajne žlice
Smjesu morate sisati u ustima do njenog potpunog rastapanja.
Obično, nakon tri dana prehlada jenjava i organizam se oporavlja. Mnogi navode da su zaustavljali prehladu ovom smjesom, bez ikakvih tableta.
Ovu smjesu možete također koristiti u kompleksnom liječenju respiratornih oboljenja, uzimajući po 1 čajnu žličicu tri puta dnevno u toku tjedna.
Možete je dodavati u mlijeko ili čaj.
Treba znati
Ako uzimate bilo kakve lijekove, konzultirajte se sa svojim liječnikom. Pogotovo, ako patite od hemofilije i hipertonije, jer kurkuma razrjeđuje krv i snižava tlak, mada će za većinu ovo biti samo veliki plus.
Ali, pored snižavanja tlaka, kurkuma može izazvati pad razine šećera u krvi. Osobe, koji pate od dijabetesa, također se moraju konzultirati sa svojim liječnikom.
Ali, ono što je zaista opasno – konzumirati kurkumu ako imate bolest žučnog mjehura i taloženja kamenca u njoj, jer kurkuma uzrokuje kontrakciju mišića žučne vrećice.
Savjet plus:
Indo-tibetanska medicina kaže:
- ako koristite kurkumu poslije obroka – djeluje na grlo i pluća
- za vrijeme obroka – na probavni sustav
- poslije obroka – na debelo crijevo i bubrege.